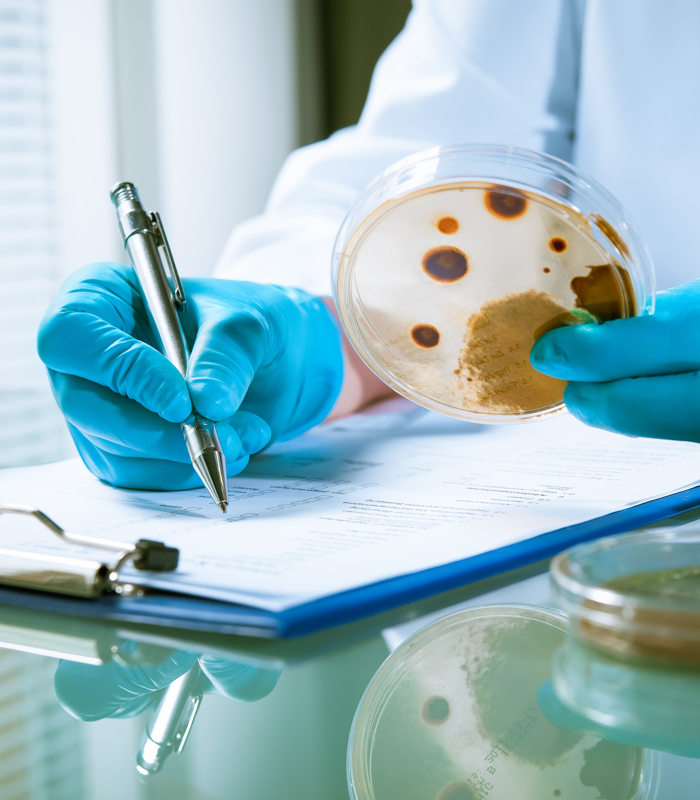

Er is momenteel veel vraag naar professionals in de voedingsmiddelenindustrie. Kennis over micro-organismen is een waardevol hulpmiddel voor deze professionals bij het verantwoord produceren van voedingsmiddelen. De basiscursus Levensmiddelenmicrobiologie leert jou die kennis en is daarom interessant voor kwaliteitsmedewerkers en andere professionals die dagelijks met voedsel(bereiding) te maken hebben.
“De cursus is praktisch toepasbaar voor de deelnemers. Zo gaan we het bijvoorbeeld hebben over een stukje interpretatie van de Europese wetgeving. Hoe interpreteer je die wetgeving en wat betekent dit voor jouw organisatie?”, vertelt docent Arianne van Velthoven. De praktische toepasbaarheid vindt je ook terug in de opzet van de cursus, deze is deels theoretisch en deels praktisch opgezet. Tijdens het practicum vormt het bepalen van aantallen aanwezige micro-organismen in monsters een belangrijk onderdeel, hierbij wordt de giet- en strijkplaattechniek toegepast. Ook wordt er aandacht besteed aan het effect van de milieufactoren pH en Aw op de groeikansen van verschillende groepen micro-organisme. Waarom groeit de ene micro-organisme door en wordt de andere geremd?
“We krijgen vaak terug dat cursisten na het volgen van deze cursus beter snappen waarom bepaalde analyses plaatsvinden in bedrijven, waarom op een bepaalde manier gehandeld wordt. Kwartjes gaan vallen tijdens het volgen van de cursus”, aldus docent Arianne van Velthoven.
Krijg jij in je werk te maken met microbiologische analyses en wil je weten waarom deze gedaan moeten worden? Wat er geanalyseerd wordt en wat de waardes van deze analyses betekenen? Meld je dan aan voor de cursus Levensmiddelenmicrobiologie.
Na het volgen van deze basiscursus kun je doorstromen naar nog meer verdiepende cursussen die HAS Hogeschool te bieden heeft, zoals de cursus Voedselveiligheid & Houdbaarheid.